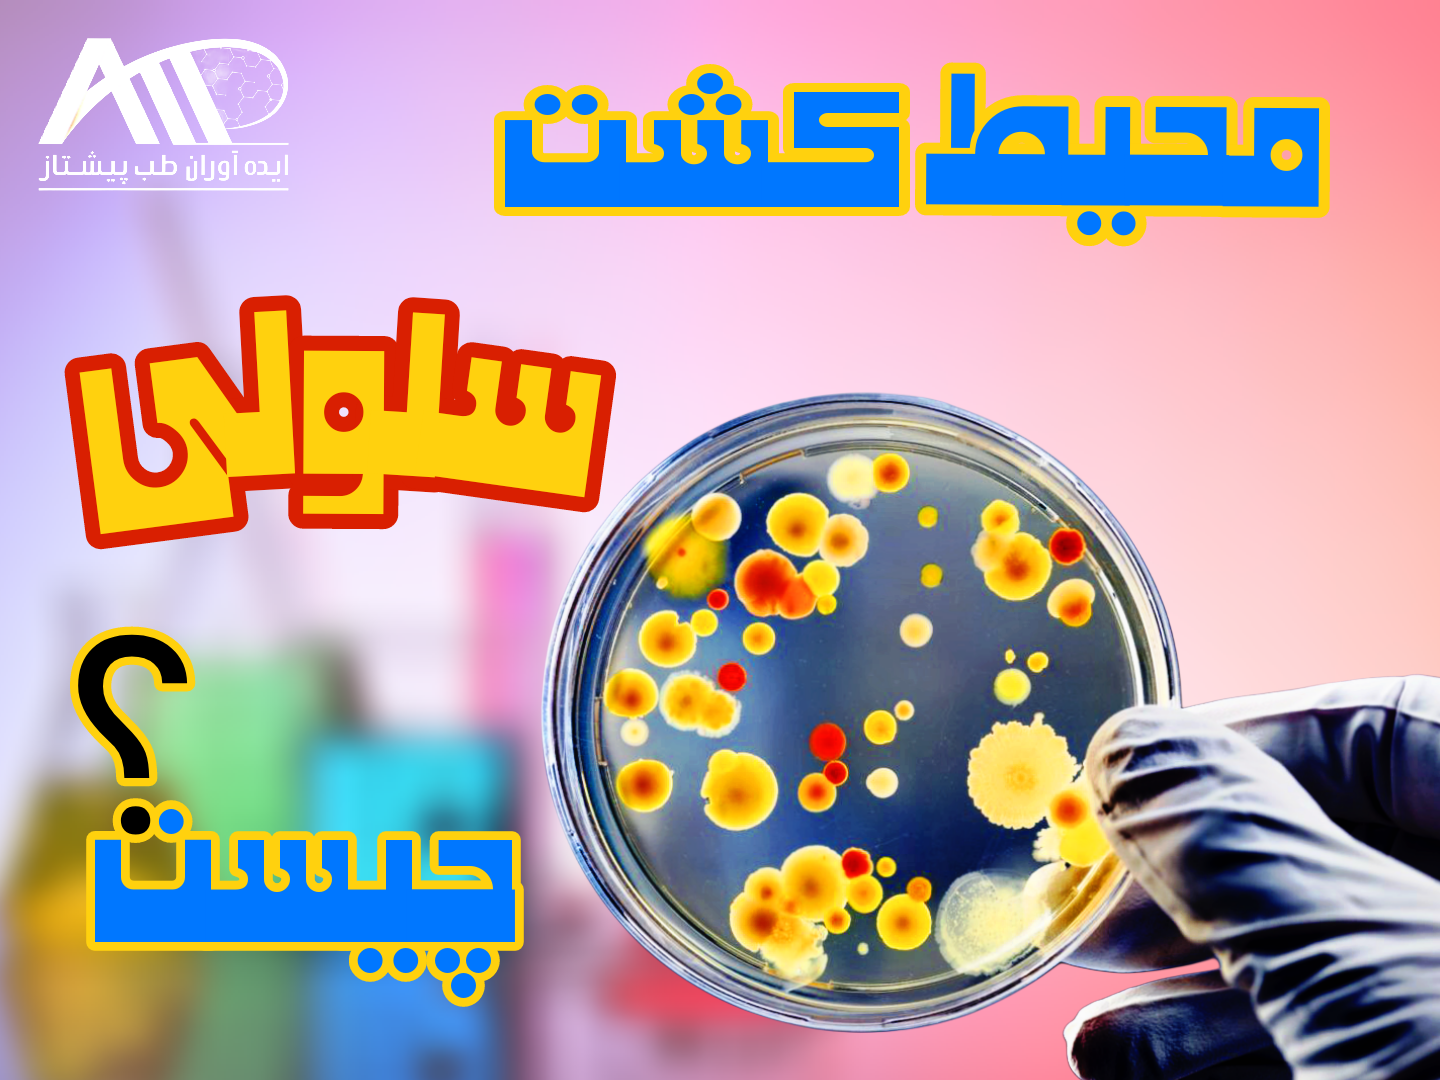
محیط کشت سلولی چیست؟ تفاوت DMEM، RPMI و MEM

محیط کشت سلولی (Cell Culture Medium) یکی از اصلیترین اجزای آزمایشهای زیستفناوری، بیولوژی سلولی، داروسازی و تحقیقات پزشکی است.
بدون انتخاب صحیح محیط کشت، رشد، تکثیر و بقای سلولها امکانپذیر نخواهد بود.
در میان محیطهای کشت سلولی، نامهایی مانند DMEM، RPMI و MEM بیش از همه شنیده میشوند.
اما تفاوت این محیطها چیست؟ هرکدام برای چه سلولهایی مناسب هستند و کدام انتخاب بهتری برای آزمایش شماست؟
در این مقاله از ایدهآوران طب پیشتاز بهصورت کامل توضیح میدهیم :
- محیط کشت سلولی چیست
- انواع محیط کشت سلولی
- تفاوت DMEM، RPMI و MEM
- کاربرد هر محیط
- معرفی برندهای معتبر Gibco و Merck

محیط کشت سلولی چیست؟
محیط کشت سلولی (Cell Culture Medium) محلولی مغذی است که شرایط لازم برای زنده ماندن، رشد و تقسیم سلولها خارج از بدن را فراهم میکند.
این محیطها شامل ترکیباتی مانند:
- آمینواسیدها
- ویتامینها
- نمکهای معدنی
- گلوکز
- بافر pH
- گاهی سرم (مانند FBS)
هستند و محیطی شبیه شرایط فیزیولوژیک بدن ایجاد میکنند.
انواع محیط کشت سلولی :
محیطهای کشت سلولی به دو دسته کلی تقسیم میشوند:
1️⃣ محیطهای پایه (Basal Media)
مانند:
- DMEM
- RPMI
- MEM
که به تنهایی یا همراه با سرم استفاده میشوند.
2️⃣ محیطهای غنیشده
که شامل:
- سرم جنین گاوی (FBS)
- گلوتامین
- آنتیبیوتیکها
هستند و برای رشد بهتر سلولها به محیط پایه اضافه میشوند.
خرید محیط کشت Gibco™ DMEM High Glucose, GlutaMAX™ Supplement, Pyruvate
محیط کشت DMEM چیست؟
DMEM (Dulbecco’s Modified Eagle Medium) یکی از پرکاربردترین محیطهای کشت سلولی است که نسخه اصلاحشده MEM محسوب میشود.
ویژگی DMEM :
- غلظت بالای گلوکز
- آمینواسید و ویتامین بیشتر
- مناسب سلولهای پرمصرف از نظر انرژی
کاربرد DMEM :
- کشت سلولهای پستانداران
- سلولهای سرطانی
- فیبروبلاستها
- سلولهای اپیتلیال
DMEM معمولاً در دو نوع High Glucose و Low Glucose عرضه میشود.

محیط کشت سلولی سرم جنین گاوی fbs گیبکو محیط کشت گیبکو کلسمید گیبکو سرم fbs گیبکو خرچنگ نعل اسبی fbs گیبکو سرم جنین گاوی محیط کشت dmem گیبکو محیط کشت rpmi گیبکو
محیط کشت RPMI چیست؟
RPMI 1640 محیطی است که ابتدا برای کشت سلولهای خونی طراحی شد.
خرید محلول Gibco™ Trypsin-EDTA 0.25%
ویژگی RPMI :
- گلوکز کمتر نسبت به DMEM
- بافر قویتر
- مناسب محیطهای معلق (Suspension)
کاربرد RPMI :
- کشت لنفوسیتها
- سلولهای خونی
- سلولهای ایمنی
- تحقیقات ایمونولوژی
RPMI انتخاب اول برای آزمایشگاههای ایمونولوژی و هماتولوژی است.
خرید محلول کلسمید در PBS (کاریومکس) برند گیبکو
محیط کشت MEM چیست؟
MEM (Minimum Essential Medium) یکی از قدیمیترین محیطهای کشت سلولی است.
ویژگی MEM :
- ترکیب سادهتر
- مواد مغذی کمتر
- مناسب سلولهای کمنیاز
کاربرد MEM :
- کشت سلولهای پایه
- مطالعات آموزشی
- سلولهای با نیاز متابولیکی پایین
MEM اغلب بهعنوان پایه برای محیطهای پیشرفتهتر مثل DMEM استفاده میشود.
خرید محیط کشت Gibco™ DMEM/F-12 GlutaMAX™
تفاوت DMEM، RPMI و MEM چیست؟
بهطور خلاصه:
- DMEM → غنیترین، مناسب سلولهای پرمصرف
- RPMI → مناسب سلولهای خونی و ایمنی
- MEM → سادهترین، مناسب سلولهای پایه
انتخاب محیط مناسب مستقیماً روی کیفیت نتایج آزمایش تأثیر میگذارد.


معرفی برندهای معتبر: Gibco و Merck
🔬 Gibco
برند Gibco (زیرمجموعه Thermo Fisher Scientific) معتبرترین تولیدکننده محیطهای کشت سلولی در جهان است:
- کیفیت ثابت
- استریل تضمینشده
- مورد تأیید مراکز تحقیقاتی و دارویی
خرید محیط کشت rpmi 1640 مدیوم گلوتامکس
🔬 Merck
برند Merck نیز یکی از پیشگامان جهانی در تولید محیطهای کشت و مواد آزمایشگاهی است و محصولات آن به دلیل دقت و خلوص بالا شناخته میشوند.

محیط کشت سلولی سرم جنین گاوی fbs گیبکو محیط کشت گیبکو کلسمید گیبکو سرم fbs گیبکو خرچنگ نعل اسبی fbs گیبکو سرم جنین گاوی محیط کشت dmem گیبکو محیط کشت rpmi گیبکو خرید محیط کشت گیبکو
خرید محیط کشت سلولی از ایدهآوران طب پیشتاز :
شرکت ایدهآوران طب پیشتاز واردکننده مستقیم:
- محیط کشت DMEM
- RPMI 1640
- MEM
- محصولات Gibco و Merck
با مزایای:
✔ ضمانت اصالت کالا
✔ تحویل سریع
✔ مشاوره تخصصی انتخاب محیط کشت
✔ مناسب مراکز تحقیقاتی، دانشگاهی و دارویی
محیط کشت سلولی سرم جنین گاوی fbs گیبکو محیط کشت گیبکو کلسمید گیبکو سرم fbs گیبکو خرچنگ نعل اسبی fbs گیبکو سرم جنین گاوی محیط کشت dmem گیبکو محیط کشت rpmi گیبکو خرید محیط کشت گیبکو
منابع :
- Freshney, R. I. Culture of Animal Cells, Wiley-Blackwell.
- Thermo Fisher Scientific – Gibco Cell Culture Media Guides.
- Merck Millipore – Cell Culture Media Technical Datasheets.
- ATCC – Cell Culture Basics Handbook.
- Alberts et al. Molecular Biology of the Cell.

دیدگاه خود را بنویسید